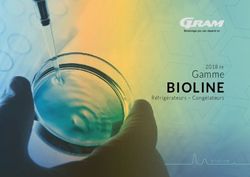
BIOLINE Gamme 2018 FR - R&eacute;frig&eacute;rateurs - Cong&eacute;lateurs

Linux temps réel sur Raspberry Pi (RPi) - Pierre Ficheux () Novembre 2014
←
→
Transcription du contenu de la page
Si votre navigateur ne rend pas la page correctement, lisez s'il vous plaît le contenu de la page ci-dessous
Linux temps réel sur Raspberry Pi (RPi)
Pierre Ficheux (pierre.ficheux@openwide.fr)
Novembre 2014
Linux TR sur RPi 1Agenda et licence
● Présentation de la carte RPi
● Distribution Raspbian
● Construction de distribution dédiée + exemple avec
Buildroot
● Solutions temps réel sous Linux
– PREEMPT-RT
– Xenomai
● Nombreuses démonstrations
Ce document est distribué sous licence Creative
Commons Share-Alike 3.0
Linux TR sur RPi 2La Raspberry Pi
● Développée en UK à des fins d'enseignement « PC
bon marché »
● Caractéristiques techniques
– Processeur BCM2835 (Broadcom) à 700 Mhz
– GPU performant, sorties vidéo composite et HDMI
– 512 Mo de RAM (GPU+CPU)
– Carte SD (pas de bootloader classique)
– USB, Ethernet (sur USB)
– GPIO, SPI, I2C
– Audio
– DSI/CSI (Display/Camera Serial Interface)
● Près de 4 millions d'exemplaires vendus à ce jour !
● Disponible à moins de 30€
Linux TR sur RPi 4La distribution Raspbian
● La Raspbian est un portage de la Debian 7.0 (wheezy)
pour la RPi
● Distribution « par défaut » pour la RPi
● Il s'agit d'une distribution classique et non pas
embarquée ni « temps réel »
# df -H
Filesystem Size Used Avail Use% Mounted on
rootfs 2.6G 2.0G 469M 82% /
...
/dev/mmcblk0p1 56M 24M 33M 30% /boot
● La distribution contient l'environnement de
développement, X11, etc.
● La plupart des utilisateurs développent en Python !
Linux TR sur RPi 7Structure de la carte SD
● La carte SD contient au départ 2 partitions (ou plus)
– Une partition VFAT de démarrage
– Une partition EXT4 contenant la distribution
● La partition VFAT contient les fichiers de démarrage,
configuration et les images noyau disponibles
kernel.img (ou bien zImage) : noyau par défaut
kernel_emergency.img : noyau de secours (statique)
cmdline.txt : configuration du noyau Linux
config.txt : configuration RPI (matérielle)
bootcode.bin : initialisation du GPU (étape 1)
start.elf + fixup.dat : initialisation du GPU (étape 2)
start_cd.elf + fixup_cd.dat : initialisation du GPU (étape 2) si < 16Mo
● Sur Raspbian, la configuration peut être modifiée avec
la commande raspi-config
Linux TR sur RPi 8Création de distribution
● Produit d’éditeur (WIND RIVER, MV, …) → €€€
● Utiliser un outil de génération : Buildroot,
OpenEmbedded, OpenWrt, LTIB
● Adapter une distribution Linux classique
– Limité au niveau matériel
– Empreinte mémoire importante
– Cas très particulier (Raspbian)
● Créer la distribution « from scratch »
– Complexe mais pédagogique
– Difficile/impossible à industrialiser:
● compilation croisée
● gestion des dépendances
● évolutions
Linux TR sur RPi 9Outil de création (build system)
● Un tel outil crée la distribution à partir des sources des
composants adaptés en appliquant des « patch »
– Il ne s'agit pas de distribution mais d'outil de création
de distribution
● L'outil ne fournit pas les sources mais les règles de
production et prend en compte les dépendances
● L'outil peut produire la chaîne croisée
● L'outil produit les différents éléments de la distribution
– Image du bootloader (u-boot.bin)
– Noyau Linux (zImage, uImage)
– Images du root-filesystem (rootfs.tar,
rootfs.jffs2, rpi-sdcard.img, ...)
Linux TR sur RPi 10Les principaux outils disponibles
● Yocto/OpenEmbedded
– Moteur écrit en Python
– Très puissant mais (très) lourd
– Basé sur des fichiers de configuration (?)
● Buildroot
– Basé sur la commande make
– Au départ un démonstrateur pour uClibc
– Désormais un véritable outil, bien maintenu !
● OpenWrt
– Dérivé de BR
– Orienté vers les IAD (Internet Access Device)
– Gère les paquets binaires
● Autres: LTIB (Freescale), PTXdist (Pengutronix)
Linux TR sur RPi 11Using Buildroot « in a nutshell »
● Aide en ligne par :
$ make help
● Utiliser une configuration pré-définie (configs) :
$ make _defconfig
● Consulter/ajuster éventuellement la configuration par :
$ make menuconfig
● Compiler par :
$ make
● Le résultat est dans le répertoire output/images :
– Bootloader (si nécessaire) → u-boot.bin
– Noyau Linux → zImage, uImage
– Image(s) du root-filesystem → rootfs.*
Linux TR sur RPi 12Test avec la RPi
● Configuration et compilation :
$ make raspberrypi_std_defconfig
$ make
● Création de la SD
$ cd output/images
$ sudo dd if=rpi-sdcard.img of=/dev/sdb
● La distribution fonctionne en mode texte mais démarre
en quelques secondes
● Pas de gestion de paquets sur Buildroot !
Linux TR sur RPi 13Linux temps réel
Linux TR sur RPi 14Rappels et définitions
● FAQ www.faqs.org/faqs/realtime-computing/faq/
● Le temps-réel est une notion de garantie et non pas de
performance
– qualité de fonctionnement (stabilité)
– temps de réponse → réaction appropriée en un temps
borné à un événement
● Ces exigences sont remplies par un « RTOS »
● « Tous » les systèmes embarqués classiques sont
temps réel (VxWorks, LynxOS, QNX, ...)
● Le temps réel est lié à des processus sensibles
(militaire, spatial, énergie, médical, transport)
Linux TR sur RPi 15Le besoin temps réel
● Initialement : contexte industriel (hard RT = TR dur)
– Pilotage matériel
– Acquisition de données
● Dans le cas du temps réel dur, il n'y a pas de tolérance
sur le comportement temps réel !
● Plus récemment : logiciel (soft RT = TR mou)
– Piles protocolaires
– Multimédia
● Portage de code depuis un RTOS vers Linux (qui lui
n’est PAS un RTOS)
Linux TR sur RPi 16Mesures des performances TR sur
Linux
● Principe :
– Programmer une tâche périodique
– Comparer la date d’échéance théorique avec la date
réelle
– La différence correspond au « jitter » (gigue)
– Tester le système avec ET sans charge !
● Outils :
– Tâche périodique: cyclictest, latency
– Manipulation de « GPIO »
– Stimulation: hackbench, stress
– Mesure : Oscilloscope, Gnuplot (tracé de courbes)
Linux TR sur RPi 17Linux standard
● Traitements souvent effectués par des processus (et
non des threads)
● Modes d'exécution d'un processus
– espace utilisateur (applicatif)
– espace noyau (entrées-sorties)
→ gestion complexe de la mémoire peu fréquente sur
un RTOS
● Préemption du traitement applicatif
– L'ordonnancement est effectué par le noyau (UNIX)
– Très différent du multitâche « collaboratif » de Windows
3.1 (et partiellement Windows 95) ou MacOS (< X)
Linux TR sur RPi 18Linux standard
● Pas de préemption « complète » en mode noyau → un
processus ne peut être interrompu dans une routine de
traitement d’interruption (ISR)
● Préemption par l'ordonnanceur
– Sur interruption timer
– Fréquence timer fixe (constante HZ = nombre de ticks
par seconde = 1000) →
● La précision de l'ordonnanceur = 1 ms (au mieux)
● Ordonnancement par niveau de priorité (POSIX)
– Priorité dynamique standard (0, ajustable avec « nice »)
→ SCHED_OTHER
– Priorité statique « temps réel » SCHED_FIFO/RR (1 à
99)
● La puissance du CPU n'améliore pas directement les
performances
Linux TR sur RPi 19Test avec noyau standard 2.4.17
(x86)
230 ms !
Linux TR sur RPi 20Test un noyau 2.6.25 (ARM9), non
chargé
5 ms
Linux TR sur RPi 21Test avec un noyau 2.6.25 (ARM9),
chargé
jitter
Linux TR sur RPi 22Test avec un noyau 2.6.25 (ARM9),
enregistrement
Linux TR sur RPi 23Raspberry Pi, noyau 3.6.11 (2013) Linux TR sur RPi 24
Test avec Ftrace (x86 non chargé) Linux TR sur RPi 25
Mesure avec Ftrace (x86 chargé)
5 ms
Linux TR sur RPi 26Mesure avec Ftrace (x86
SCHED_FIFO, chargé)
Linux TR sur RPi 27PREEMPT-RT
● Branche expérimentale pour le noyau 2.6, voir
https://rt.wiki.kernel.org
● Initié par Ingo Molnar, contributeur majeur du noyau
● Maintenu par Thomas Gleixner
● Aucun lien avec l'antique « preempt-kernel » !
● Surtout utilisé sur x86 et des processeurs performants
(TSC = Time Stamp Counter)
● Fonctionne également sur ARM (9 ou plus), Nios II,
Microblaze, ...
● Nécessite un noyau « mainline » (ou proche) mais ne
sera probablement jamais intégré à la branche officielle
● Mise en place très simple (application d'un patch)
● Mêmes API de programmation que Linux standard
Linux TR sur RPi 28PREEMPT-RT, modifications
● Threaded interrupt model → utilisation d'un thread
noyau (interruptible) pour le traitement de chaque
interruption
4 2 root SW< 0 0% 0% [sirq-high/0]
5 2 root SW< 0 0% 0% [sirq-timer/0]
...
6 2 root SW< 0 0% 0% [sirq-net-tx/0]
● Prévention des inversions de priorité (par héritage)
● Timers noyau haute précision (API hrtimer)
● Réécriture complète des mécanismes de
synchronisation (spinlock → mutex)
● Compatibilité avec Ftrace pour la mise au point
● La quasi-totalité du noyau est préemptible, mais reste
un noyau Linux, donc très volumineux !
Linux TR sur RPi 29Configuration PREEMPT-RT
HRTIMER
IRQ = kernel thread
Linux TR sur RPi 30Linux PREEMPT-RT
Utilisation et performances
● Changements significatifs du code noyau
– Sémantique de verrouillage des sections critiques
– Inspection nécessaire de tous les composants
– Volume du patch important
● Utilisation de mlockall() → verrouillage des pages
mémoire en RAM
● Le coût de la préemption peut être important si le
nombre de tâches TR augmente
● Temps de latence maximum nettement amélioré
– dépend largement de la plate-forme matérielle (TSC)
– dépend de la configuration logicielle
– Bons résultats sur x86 pour les versions récentes,
2.6.30 et plus
Linux TR sur RPi 31PREEMPT-RT, mesures de
performances
● PREEMPT-RT peut être intégré à Buildroot et utilisé
avec le paquet rt-tests
● Utilisation du programme cyclictest avec 5 threads
temps réel (période = 1 ms) :
# cyclictest -p 99 -t 5 -n
● Charge avec hackbench (création de N processus
communiquant entre eux par pipe)
# hackbench -p -g 20 -l 1000 1000 messages
● Plate-forme Atom/x86 (N550) 800 tâches !
– gigue avec noyau standard : 16 ms !
– gigue avec PREEMPT-RT : < 50 µs :-)
● Sur RPi, la gigue tourne autour de 100 à 150 µs
Linux TR sur RPi 32Test PREEMPT-RT sous RPi
● Sans charge
# cyclictest -p 99 -t 5 -n -q
T: 0 ( 67) P:99 I:1000 C: 4120 Min: 14 Act: 23 Avg: 23 Max: 55
T: 1 ( 68) P:98 I:1500 C: 2747 Min: 14 Act: 22 Avg: 32 Max: 83
T: 2 ( 69) P:97 I:2000 C: 2177 Min: 15 Act: 21 Avg: 22 Max: 53
T: 3 ( 70) P:96 I:2500 C: 1741 Min: 15 Act: 27 Avg: 24 Max: 60
T: 4 ( 71) P:95 I:3000 C: 1451 Min: 15 Act: 25 Avg: 21 Max: 55
● Avec charge hackbench
T: 0 ( 81) P:99 I:1000 C: 28485 Min: 14 Act: 21 Avg: 26 Max: 77
T: 1 ( 82) P:98 I:1500 C: 18990 Min: 14 Act: 24 Avg: 28 Max: 88
T: 2 ( 83) P:97 I:2000 C: 14243 Min: 15 Act: 41 Avg: 32 Max: 156
T: 3 ( 84) P:96 I:2500 C: 11394 Min: 15 Act: 28 Avg: 36 Max: 165
T: 4 ( 85) P:95 I:3000 C: 9495 Min: 15 Act: 28 Avg: 35 Max: 79
● Noyau standard
T: 0 ( 73) P:99 I:1000 C: 22392 Min: 15 Act: 28 Avg: 28 Max: 2042
T: 1 ( 74) P:98 I:1500 C: 14928 Min: 16 Act: 20 Avg: 32 Max: 1616
T: 2 ( 75) P:97 I:2000 C: 11196 Min: 16 Act: 115 Avg: 38 Max: 1376
T: 3 ( 76) P:96 I:2500 C: 8957 Min: 16 Act: 37 Avg: 37 Max: 1718
T: 4 ( 77) P:95 I:3000 C: 7464 Min: 17 Act: 38 Avg: 36 Max: 1523
Linux TR sur RPi 33Mesure avec Ftrace (x86
PREEMPT-RT, chargé)
Linux TR sur RPi 34Linux + co-noyau
● Ajout d'un « co-noyau » pour la gestion du temps-réel
– Sous-système temps-réel intégré à un module noyau
– Patch de « virtualisation » des interruptions
● Différents modèles :
– Noyau uniquement (RTLinux/Free, www.rtlinuxfree.com)
→ version libre obsolète
– Noyau & espace utilisateur, semi-intégration Linux (RTAI,
www.rtai.org)
– Noyau & espace utilisateur, intégration Linux complète
(Xenomai, www.xenomai.org)
Linux TR sur RPi 35Linux + co-noyau
Fonctionnement
● Séparation entre le composant temps-réel et Linux
– Ordonnanceur temps-réel spécifique
– Pas de dépendance sur les sections critiques Linux :-)
● Virtualisation de la gestion d'interruptions Linux
– Routage prioritaire des IRQs vers le co-noyau
● Linux comme tâche idle du co-noyau
● Volume du patch noyau plus faible qu'avec PREEMPT-
RT → 11000 lignes pour Xenomai/ADEOS
● Se rapproche de la technique de « para-virtualisation »
des hyperviseurs (adaptation de l'OS)
Linux TR sur RPi 36RTLinux
● Projet universitaire (NMT) développé par Victor
Yodaiken et Michael Barabanov en 1999
● Produit commercial développé par FSMLabs
● Dépôt d’un brevet logiciel → conflit avec la FSF
● Vendu à WIND RIVER en 2007
● Développement en espace noyau (?)
● Version GPL obsolète (2.6.9) retirée par WIND RIVER
Linux TR sur RPi 37Architecture RTLinux
User space Linux process
Linux process (IHM)
(data fetching)
Real time Linux
FIFO modules
Real time task 3
application
Linux kernel
Real time task 1 Real time task 2
Module sched Module posixio
Linux interrupt handler
Software interrupt
Real time kernel: RTLinux
Hardware interrupt
Hardware – interrupts controller
Linux TR sur RPi 38RTAI
● Real Time Application Interface
● Un « fork » de RTLinux développé au DIAPM de l’école
polytechnique de Milan → Dipartimento di Ingegneria
Aerospaziale (Paolo Montegazza)
● Utilisé au DIAPM pour des travaux d’enseignement et
de recherche
● Position douteuse / brevet logiciel FSMLabs
● Collaboration avec Xenomai entre 2003 et 2005 →
RTAI/Fusion
● Fonctionne surtout sur x86
● Toujours actif mais peu d’évolution → version 3.8 en
février 2010, 3.9 en août 2012, 4.0 en décembre 2013
Linux TR sur RPi 39Xenomai
● Autrefois lié à RTAI
● Indépendant depuis 2005
● Développement de tâches temps réel en espace
utilisateur :-)
● API de pilotes noyau → RTDM (Real Time Driver
Model)
● Projet Linux/TR le plus avancé (et performant) à ce jour
Linux TR sur RPi 40Linux + co-noyau, synthèse
● Changement minimal sur le noyau Linux
– patch de virtualisation d'interruptions
– pas d'impact sur l'écriture de code noyau classique
● Impact sur l'écriture de code temps-réel !
– utilisation d'APIs fournies par le co-noyau
– notion de domaine d'exécution (temps-réel / normal)
● Garanties temps-réel fortes
– ordonnanceur spécifique indépendant
– sous-système temps-réel bien délimité
– Avec Xenomai ou RTAI, gigue maximale de l’ordre de 10
µs sur Atom N550, 40 µs sur RPi !
Linux TR sur RPi 41Test Xenomai 2.6.25/ARM9 (2011) Linux TR sur RPi 42
RPi sous Xenomai (2013) Linux TR sur RPi 43
Historique Xenomai
● Créé en 2001 par Philippe Gerum→ émulation d’API
RTOS (Xenodaptor)
– Xenomai v0.5 – septembre 2001
– Xenomai v1.1.1 – décembre 2002
● Intégration à RTAI en 2003
– RTAI/fusion v0.1 – juin 2004
● Indépendance reprise en 2005
– Xenomai 2.0 – octobre 2005 (RTAI/fusion v0.9.1)
– Xenomai 2.1 – mars 2006
– ...
– Xenomai 2.6.0 – novembre 2011
– Xenomai 2.6.3 – octobre 2013
– Xenomai 3.0 – 2014 (Git)
Linux TR sur RPi 44What is Xenomai ?
● Xenomai est un sous-système temps-réel de Linux
– Faible latence
– Programmation de tâches possible en espace
utilisateur
– API de pilotes temps réel (RTDM) !
● Intégré à Linux → « Real-time sub-system »
● Supporte de nombreuses architectures
● Dispose de « skins » permettant d'émuler des API
temps réel (POSIX, VxWorks, VRTX, uITRON, ...)
● Faible empreinte mémoire
● Plus complexe à mettre en œuvre que PREEMPT-RT
mais performances supérieures (5 à 10 fois)
● Licence GPL (cœur), LGPL (interfaces, espace
utilisateur)
Linux TR sur RPi 45Architecture générale
● Xenomai utilise un « hyperviseur » (ADEOS) pour
partager le matériel avec le noyau Linux
● Un processus contient des threads TR et TP (Linux)
Processus Linux
pilote TR
API TR
noyau TR
Domaine A Domaine B
« hyperviseur »
Linux TR sur RPi 46Architecture générale
● Adaptabilité
– cœur de RTOS générique → « nucleus »
– spécialisation d'interfaces ou skins (souvent POSIX)
● Modèle de programmation
– espace noyau → le plus souvent pour les pilotes
RTDM
– espace utilisateur standard par les « skins »
– L'application Linux est répartie sur les deux noyaux
(Linux et Xenomai) ou « domaines »
● Couches d'abstraction d'architecture hôte SAL/HAL
– rassemble les dépendances matérielles de la cible
● Multi plates-formes
– arm, blackfin, i386, ia64, powerpc32, powerpc64,
nios2, sh4
Linux TR sur RPi 47Architecture générale
Code applicatif VxWorks Code applicatif POSIX
glibc Xenomai glibc Xenomai
libvxworks libpthread
Xenomai Skin VXWorks Skin POSIX
Nucleus (RTOS générique)
SAL/HAL
Adeos I-Pipe
Linux TR sur RPi 48Utilisation des domaines
libpthread_rt
Code applicatif VxWorks Code applicatif POSIX
Xenomai Xenomai
glibc glibc
libvxworks libpthread
Appels système
Pile réseau Xenomai RTOS
Noyau Linux
VFS/FS ... Noyau
Adeos I-Pipe
Hardware
Linux TR sur RPi 49Configuration du noyau
● Nouvelle entrée Real-time sub-system dans le menu
principal
Linux TR sur RPi 50Configuration du noyau, suite
sélection « statique »
spécificités matérielles
« skins »
incompatibilité de config
Linux TR sur RPi 51Test de fonctionnement
● On peut utiliser latency fourni avec Xenomai
– tâche périodique à partir de 100 µs (1ms sur RPi)
– affichage du jitter (min, avg, max, best, worst)
– « Overrun » et migration de mode (msw)
● Exemple sur RPi
# echo 0 > /proc/xenomai/latency
# latency
== Sampling period: 1000 us
== Test mode: periodic user-mode task
== All results in microseconds
warming up...
RTT| 00:00:01 (periodic user-mode task, 1000 us period, priority 99)
RTH|----lat min|----lat avg|----lat max|-overrun|---msw|---lat best|--lat worst
RTD| 2.000| 5.000| 31.000| 0| 0| 2.000| 31.000
RTD| 2.000| 5.000| 21.000| 0| 0| 2.000| 31.000
RTD| 2.000| 5.000| 19.000| 0| 0| 2.000| 31.000
...
Linux TR sur RPi 52Test de fonctionnement
● On peut charger le système Linux avec la commande
hackbench ou avec un « flood ping ».
# hackbench -p -g 20 -l 1000
# ping -f adresse_RPi
● On note la variation sur le domaine Xenomai
RTD| 2.000| 5.000| 24.000| 0| 0| 2.000| 25.000
RTD| 2.000| 5.000| 25.000| 0| 0| 2.000| 25.000
RTD| 3.000| 21.000| 36.000| 0| 0| 2.000| 36.000
RTD| 3.000| 21.000| 36.000| 0| 0| 2.000| 36.000
RTD| 3.000| 21.000| 32.000| 0| 0| 2.000| 36.000
RTD| 3.000| 21.000| 33.000| 0| 0| 2.000| 36.000
RTD| 2.000| 19.000| 33.000| 0| 0| 2.000| 36.000
● On note le retour à la valeur moyenne lors de l'arrêt de la
charge
RTD| 2.000| 5.000| 21.000| 0| 0| 2.000| 36.000
RTD| 2.000| 5.000| 23.000| 0| 0| 2.000| 36.000
...
Linux TR sur RPi 53ADEOS
● Adaptative Domain Environment for Operating Systems
● Proposé par Karim Yaghmour en 2002 pour contourner
le brevet logiciel de RTLinux / FSMLabs
● Virtualisation de ressources matérielles →cohabitation
de plusieurs noyaux sur une même machine
● Basé sur un principe de « pipeline d'interruptions » (I-
Pipe)
● Organisation en domaines avec priorité (topmost pour
Xenomai) → ordonnancement
– Composant logiciel basé sur un micro-noyau
– Notifié par ADEOS lors d'événements (interruption,
trappe, appel système, ...)
● Existe uniquement sous la forme d'un « patch » pour le
noyau Linux
Linux TR sur RPi 54I-Pipe ADEOS
priorité topmost
Linux TR sur RPi 55Principe du I-Pipe
● Le I-Pipe est démarré par le domaine « racine » (Linux)
→ initialisation dans start_kernel()
● Le contrôleur d'interruption matériel est uniquement
piloté par ADEOS
● Pour chaque domaine, masque d'interruption au niveau
logiciel et non plus au niveau matériel
● Pour chaque interruption, le domaine peut :
– Accepter → traitement immédiat
– Ignorer → traitement différé → blocage du domaine
– Écarter → propagée au domaine suivant
– Terminer → non propagée
● La réception d'interruption matérielle est possible
pendant le blocage du domaine → pas de perte
d'IRQ :-)
Linux TR sur RPi 56Principe du I-Pipe, suite
● Traitement des interruptions (x86)
– cli (CLear Interrupt) → ipipe_stall()
– sti (SeT Interrupt) → ipipe_unstall()
● Propagation au domaine suivant
– ipipe_propagate_irq()
Linux TR sur RPi 57Blocage du domaine racine
ipipe_stall_pipeline_from()
domaine bloqué → sauvegarde de l'IRQ
Linux TR sur RPi 58Déblocage du domaine racine
ipipe_unstall_pipeline_from()
traitement de l'IRQ sauvegardée
Linux TR sur RPi 59Domaines d'exécution
● Dualité d’ordonnancement sur 2 domaines
– Domaine Xenomai, déterministe
– Domaine Linux, non déterministe
● Exécution d'une tâche temps-réel
– Mode primaire (domaine Xenomai)
– Mode secondaire (domaine Linux)
● Migration de modes
– Automatique sur appels système
– Interceptée par le signal SIGDEBUG
– Source de « jitter » !
Linux TR sur RPi 60Migration de domaine sur syscall
Appel système Linux (glibc)
Domaine
Linux
Domaine
Xenomai
Migration d'appel système
Exécution tâche temps-réel Appel système Xenomai (skins)
Linux TR sur RPi 61Conclusions
● La RPi n'est pas une carte industrielle mais permet de
tester des fonctionnalités disponibles sur d'autres
cartes plus performantes (Cortex-A8/A9, i.MX6)
● Xenomai est beaucoup mieux adapté à l'embarqué que
PREEMPT-RT
● La mise en place reste cependant plus délicate et
nécessite une architecture particulière pour l'application
ainsi que des pilotes dédiés !
Linux TR sur RPi 62Bibliographie
● http://www.framboise314.fr/38-millions-de-raspberry-pi-vendus
● http://buildroot.uclibc.org
● http://www.yoctoproject.org
● http://www.xenomai.org
● https://rt.wiki.kernel.org
● http://www.blaess.fr/christophe/livres/solutions-temps-reel-sous-linux
● http://www.blaess.fr/christophe/category/raspberry-pi
● http://www.linuxembedded.fr/2013/01/preempt-rt-sur-raspberry-pi
● http://www.linuxembedded.fr/2013/07/rtems-sur-raspberry-pi
● http://www.linuxembedded.fr/2014/07/electronique-simple-pour-gpio
● http://xenomai.org/2014/06/porting-a-posix-application-to-xenomai
● http://www.xenomai.org/documentation/trunk/html/api
● http://francois.touchard.perso.luminy.univ-amu.fr/3/LinuxAvance/C1-intro.pdf
● http://francois.touchard.perso.luminy.univ-amu.fr/3/LinuxAvance/C4-RTDM.pdf
● https://delog.wordpress.com/2014/09/16/embedded-linux-system-for-raspberry-pi-with-
yocto-project/
Linux TR sur RPi 63Vous pouvez aussi lire